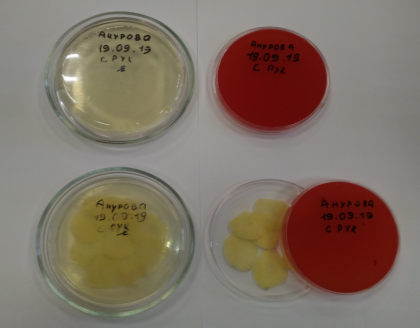
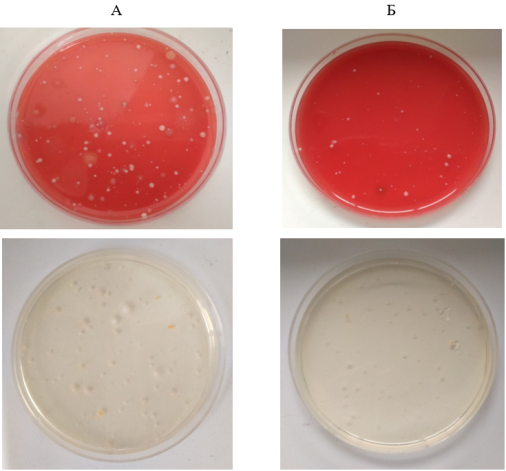

В работе проведены исследования по определению фитонцидной активности чеснока посевного. Были выделены микроорганизмы из воздуха 4 «Д» класса ГБОУ Школы № 1018 города Москвы. Проведено сравнительное изучение скорости роста микроорганизмов в присутствии чеснока посевного и без него. Показано, что летучие фракции этого растения способны подавлять рост микроорганизмов.
Ключевые слова: чеснок, фитонциды, противомикробное действие, микрофлора.
Проблема профилактики заболеваемости учащихся острыми респираторными бактериальными инфекциями в школах является одной из актуальных задач. Некачественный воздух помещений является одной из главных причин возникновений заболеваний органов дыхания у детей. Возникает вопрос о снижении уровня микробиологического загрязнения воздушной среды с целью минимизация риска заболеваемости [1]. Отличным естественным средством является уникальная особенность всех растений, которая заключается в постоянном выделении в окружающую среду летучих веществ, называемыми фитонцидами. Фитонциды — это выделяемые растениями бактерицидные (убивающие бактерии), фунгицидные (противогрибковые) летучие вещества, являющиеся одним из факторов естественного иммунитета. К таким растениям относится чеснок посевной, в котором содержатся эфирные масла, обуславливающие характерный вкус и запах чеснока и обладающие антимикробными свойствами [2].
История чеснока насчитывает свыше четырех тысячелетий — уже тогда он активно использовался человеком. Его родиной считаются страны Азии, Кавказа, Средиземноморья. Упоминания о чесноке впервые встречаются в письменностях древних шумеров. В Древнем Египте чеснок был обязательным компонентом в питании строителей пирамид. Римские воины использовали чеснок для укрепления мужской силы и подъема боевого духа. Перед сражениями гладиаторы съедали по целой головке чеснока, чтобы одержать победу над соперником. Из истории происхождения чеснока известно, что в Древней Греции его называли «вонючей розой». Ятросы (врачи) варили чеснок в вине, смешивали с луком, медом, различными травами, изготавливали мази, линименты, настойки; наряду с опиумом чеснок считался одним из главных лечебных средств в ту пору. В Средние века чеснок использовали как предохранительное средство от чумы, холеры, брюшного тифа. В Германии он помогал бороться с дизентерией, холерой и брюшным тифом и туберкулезом, во Франции — с холерой, тифом и легочным туберкулезом. «Уксус четырех воров», — именно так назвали чеснок в 1722 году во Франции и применяли во время эпидемии бубонной чумы [3, 4].
В русской народной медицине чеснок до сих пор широко применяется, и традиционная медицина не отрицает эффективности использования чеснока при ряде заболеваний [5].
В сезон простуд в некоторых учебных заведениях раскладывают измельченный чеснок в помещениях, население потребляет этот продукт в пищу. Решили выяснить действительно ли данная процедура несет положительный результат в снижении заболеваемости простудными инфекциями.
Таким образом, сформулировали следующую гипотезу: предположительно, летучие фракции чеснока оказывают различное действие на микроорганизмы. На основании этого можно определить эффективность чеснока в качестве профилактического средства при простудных заболеваниях.
Цель исследования: изучить фитонцидную активность чеснока.
В качестве объекта исследования был выбран выращенный на дачном участке чеснок посевной.
Методика эксперимента: теоретическая — анализ информационных источников, сравнения; эмпирический мониторинг — лабораторные наблюдения, фотосъёмка; математическая — сравнительный анализ; экспериментальная — постановка опыта.
Для изучения эффективности чеснока против микрофлоры 4 «Д» класса в лаборатории Бактериофагов ФБУН МНИИЭМ им Г. Н. Габричевского брали плотные питательные среды для культивирования микроорганизмов.
Чашки Петри с питательными средами с открытыми крышками расставляли в классе на весь учебный день (5 уроков). Чашки расставляли по всему кабинету: у входа в кабинет, на столе у учителя, на подоконниках, на шкафах и на нескольких партах.
Затем чашки помещели на одни сутки в термостат с постоянной температурой 37±1°С. За это время и при данной температуре происходит активный рост и размножение микроорганизмов. В часть чашек положили резанный чеснок. И через сутки оценивали результаты эксперимента. На рисунке 1 представлены чашки Петри с питательными средами в начале эксперимента с помещенным внутрь чашек чесноком и без него.
Рис. 1. Чашки Петри с питательными средами с помещенным внутрь чашек чесноком и без него
Результаты исследования. Оценивали результат по количеству колоний (пятна, и точки на питательной среде) и их размеру. Как видно из рисунка 2 на чашках Петри, где был чеснок, количество и размер колоний меньше чем на чашках Петри, куда чеснок не помещали. Это говорит о том, что эфирное масло чеснока способно оснанавливаль рост и размножение микроорганизмов.
Рис. 2. Чашки Петри, в которых не было чеснока (А) и Чашки Петри с чесноком (Б)
Вывод: Установили что летучие фракции чеснока, которые извлекаются из резанного чеснока, обладают выраженным фитонцидным действием, то есть способны подавлять рост и размножение микроорганизмов. Можно предположить, что использование свежего резанного чеснока для обеззараживания воздуха имеет определенную эффективность и может быть использовано как безопасный и безвредный способ профилактики инфекционных заболеваний, особенно в период эпидемий.
Литература:
- Петров В. А., Медведева Т. О., Цопа Т. В., Невинский А. Б., Терпеливая О. П., Лаврентьев О. Э. Современные аспекты профилактики острых респираторных заболеваний у детей //Вестник Волгоградского государственного медицинского университета, 2007 г., С. 14–18.
- Блок Э. Химические основы биологического действия чеснока и лука.- 1985.- № 5, С. 59- 65
- https://med.wikireading.ru/28149. История применения чеснока в медицине [дата обращения 14.10.2019 г.]
- https://nmedik.org/istoriya-ispolzovaniya-chesnoka.html. История использования чеснока [дата обращения 14.10.2019 г.]
- Киселева Т. Л., Нефедова А. В. Лук и чеснок в фитотерапии и гомеопатии // Традиционная медицина. 2004. № 1 (2). С. 23–32.

